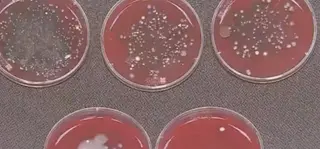
How Many Bacteria Will Be When Wearing A Mask for One Day?

How Long Can The Disposable Protective Mask Be Used
It is necessary to replace the masks when it is polluted, damaged or result in difficult breathing due to increased resistance.
Factors affecting the life of a mask include damaged nose clips, loose headbands, deformed masks, odors or dirt on the masks and increased breathing resistance. When this happens, it should be replaced in time.
Because pathogenic microorganisms such as viruses are infectious, used protective masks may contain some infectious substances. If you touch the surface of a contaminated mask with your hands, the pathogenic microorganisms may be taken to other places (such as door handles), and the touch on your mouth and nose also causes you infected, so make sure to clean your hands before and after wearing the mask.
If you plan to reuse the mask, store it in a clean, dry place away from any possible contamination. Particulate Protective masks (sometimes called disposable masks) cannot be reused after cleaning or disinfection. Therefore, it is proper to discard the masks that have contacted with infectious substances for safety concern.
Factors affecting the life of a mask include damaged nose clips, loose headbands, deformed masks, odors or dirt on the masks and increased breathing resistance. When this happens, it should be replaced in time.
Because pathogenic microorganisms such as viruses are infectious, used protective masks may contain some infectious substances. If you touch the surface of a contaminated mask with your hands, the pathogenic microorganisms may be taken to other places (such as door handles), and the touch on your mouth and nose also causes you infected, so make sure to clean your hands before and after wearing the mask.
If you plan to reuse the mask, store it in a clean, dry place away from any possible contamination. Particulate Protective masks (sometimes called disposable masks) cannot be reused after cleaning or disinfection. Therefore, it is proper to discard the masks that have contacted with infectious substances for safety concern.
Send your message to this supplier
Related Articles from the Supplier
How Long Can The Disposable Protective Mask Be Used
- Mar 24, 2020
How to Deal with Used Masks?
- May 26, 2020
How to Choose Masks?
- Jun 01, 2020
How to Relieve from the Sultry Mask?
- Jul 14, 2020
How the COVID-19 Pandemic in USA Could End?
- Oct 14, 2020
Related Articles from China Manufacturers
How Long Can The Disposable Protective Mask Be Used
- Mar 24, 2020
How Long Can Vacuum-packed Rice Cakes Last?
- Aug 27, 2020
How Long Does an Electric Car Battery Last?
- Jan 03, 2025
Related Products Mentioned in the Article
Supplier Website
Source: https://www.facemaskssupplier.com/news/how-long-can-the-disposable-protective-mask-be-used.html